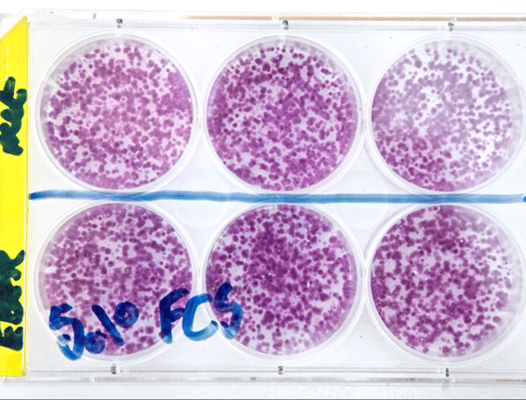

Research Projects
We have supported 73 clinical trials and research projects that will help us bring new treatments and technology to people with cancer – ultimately saving more lives. Read some of the projects we are currently funding below.
The Pink Drink
Professor Colin Watts showed that a drug that makes brain tumours glow pink under UV light can help surgeons find and remove cancer cells.
If you were searching for something in a dark room, it would be very hard to find. But if someone shone a spotlight directly on what you were looking for, it would be much easier!
This is a bit like surgeons looking for cancer cells amongst healthy cells in the brain. Surgery is a great way to remove the cancer, but it’s tricky. It can be hard for doctors to spot and remove all the cancer cells, while leaving healthy cells intact.

To combat this, Professor Colin Watts tested a drug called 5-ALA, which makes certain brain tumour cells glow fluorescent pink under UV light.
He showed that if patients have a drink containing 5-ALA before their surgery, surgeons can shine a fluorescent light on the brain and expose the most aggressive type of cancer cells, which are crucial for the surgeon to remove.
This drug, now known as The Pink Drink, is available across the NHS, improving survival and quality of life for people with brain tumours.
Beating cancer with bubbles
Our scientists designed a method that could make chemotherapy kinder, by delivering drugs with microscopic bubbles.
Chemotherapy is one of the best ways we can treat cancer.

But chemo drugs can kill healthy cells as well as cancer cells, which is why there are unpleasant side effects. Thanks to SU2C, Professor Eleanor Stride developed a futuristic way to make chemo more targeted.
Excitingly, the team showed that their technique worked in mice with bladder cancer, and it caused fewer side effects. Now, Professor Stride is working on taking the technology into clinical trials and investigating if it could be used for other cancer types. She hopes that her method could one day make chemotherapy kinder for those affected by cancer.
Viruses vs cancer
Dr Alan Parker is using viruses to beat cancer.
Viruses are the scourge of the body.
They infect us and make us ill until our immune system clears them. But! We might be able to use them to help make us healthy too. How? By engineering viruses to attack cancer cells!
With support from SU2C, Professor Alan Parker and his team at Cardiff University are modifying a type of virus that normally causes coughs and colds to infect cancer cells without infecting healthy cells. These modified viruses can also activate the immune system allowing it to recognise and destroy the cancer cells.
This surprising approach could lead to new targeted treatment options for people with cancer.